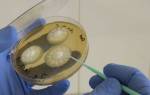

Лекарство Кетотифен – это антигистаминный небронходилатирующий препарат. Действующее вещество – кетотифен (Ketotifen) в виде кетотифена фумарата. Лекарственное средство применяется для системного лечения аллергии. Инструкция по применению Кетотифена составлена на основании рекомендаций по применению производителей: Ирбитский химико-фармацевтический завод (Россия), Розфарм ООО (Россия), Обновление ПКФ (Россия), Борисовский завод медицинских препаратов (Беларусь), Sopharma (Болгария).
Состав и форма выпуска
Препарат выпускается в виде таблеток, сиропа и глазных капель. В зависимости от диагноза, врач назначает форму и дозировку.
|
Форма выпуска |
Действующее вещество |
Дозировка |
Описание |
Вспомогательные вещества |
Количество в упаковке |
|
таблетки |
Кетотифена фумарат |
1 мг |
Плоскоцилиндрические таблетки с фаской белого цвета |
лактоза, МКЦ, кремния диоксид коллоидный, магния стеарат, тальк |
10шт на блистере, 3 конвалюты в упаковке |
|
сироп |
1 мг/5 мл |
бесцветная или бледно-желтая вязкая жидкость с фруктовым запахом |
натрия бензоат, мальтит жидкий, сахарин натрия, натрия фосфат додекагидрат, кислота лимонная моногидрат, кислота фумаровая, глицерин, гидроксиэтилцеллюлоза, ароматизатор, вода очищенная |
100 мл во флаконе темного стекла или темного полиэтилентерефталата коричневого цвета с полиэтиленовым колпачком |
|
|
Глазные капли |
0,25 мг/мл |
прозрачная или немного опалесцирующая бесцветная или с желтоватым оттенком жидкость |
гидроксид натрия, вода очищенная, декстран, хлорид бензалкония, трилон Б, хлорид натрия, кислота лимонная |
5мл во флаконе–капельнице |
Мнение врача:
Кетотифен – это препарат, который широко используется в педиатрии для лечения аллергических заболеваний, таких как астма и аллергический ринит. Врачи отмечают, что кетотифен обладает противоаллергическим и противовоспалительным действием, что делает его эффективным средством для снижения симптомов аллергии. Инструкция по применению кетотифена подробно описывает дозировку и способы применения, что позволяет врачам назначать его пациентам с высокой степенью уверенности. Отзывы пациентов также подтверждают эффективность препарата, особенно в комбинации с другими лекарственными средствами. В целом, мнение врачей о кетотифене положительное, и они рекомендуют его как одно из средств лечения аллергических заболеваний.
https://youtube.com/watch?v=GwlIXAMM65k
Механизм действия Кетотифена
Препарат обладает противоаллергическим (антигистаминным) действием, притормаживает высвобождение гистамина и иных медиаторов из тучных клеток, является ингибитором н1-рецепторов, угнетая фосфодиэстеразы. В результате блокады медиаторов возрастает количество цАМФ, стабилизируются мембраны тучных клеток. Действующее вещество подавляет тромбоцит–активирующий фактор. Максимальная концентрация в плазме отмечается через 2–4 часа. Метаболизируется большая часть дозы в печени.

Интересные факты
-
Кетотифен является антигистаминным препаратом второго поколения, который используется для профилактики и лечения аллергических заболеваний, таких как астма, сенная лихорадка и аллергический ринит.
-
Кетотифен блокирует действие гистамина, вещества, которое высвобождается из тучных клеток при аллергической реакции. Это помогает уменьшить симптомы аллергии, такие как чихание, насморк, зуд в глазах и носу, затрудненное дыхание и кожная сыпь.
-
Кетотифен обычно хорошо переносится, но некоторые люди могут испытывать побочные эффекты, такие как сонливость, сухость во рту, тошнота, головная боль и головокружение.

Кетотифен – гормональный или нет
Гормоны – это биологически активные вещества органического происхождения. Кетотифена фумарат не является гормональным препаратом, это сложное неорганическое химическое соединение. У некоторых пациентов при приеме лекарства наблюдалось увеличение массы тела. Такой эффект обусловлен не гормональным составом лекарства, а одним из побочных проявлений – повышением аппетита.
Опыт других людей
Кетотифен – это препарат, который часто рекомендуют при аллергических реакциях и астме. Он блокирует действие гистамина, снижая отеки и зуд. Многие отмечают его эффективность и быстрое действие. Однако перед использованием важно проконсультироваться с врачом и ознакомиться с инструкцией. Отзывы пользователей также полезны для понимания опыта применения препарата.
Показания к применению
По инструкции медикамент применяют для профилактики и лечения аллергических реакций. Основные проявления аллергии, при которых эффективен препарат:
-
бронхиальная астма,
-
бронхит аллергического генеза,
-
сенная лихорадка,
-
аллергический ринит,
-
атопический дерматит,
-
крапивница,
-
аллергический конъюнктивит.
Способ применения и дозировка
В зависимости от заболевания и возраста пациента, врач определяет форму и дозировку лекарства. Для лечения аллергических реакций взрослых и детей от 3 лет применяются таблетки или сироп, детям от 6 месяцев до 3 лет показан сироп. При аллергическом конъюнктивите взрослым и детям от 3 лет назначается препарат в виде офтальмологических капель.
Таблетки Кетотифен
Стандартная терапевтическая доза взрослых составляет 2 мг в сутки (по таблетке утром и вечером). Больным, у которых ярко проявляется седативный эффект, Кетотифен назначают по схеме с постепенным повышением дозировки на протяжение 5 дней от 1 до 2 таблеток в сутки. В случае необходимости суточную дозу можно увеличить до 4 мг. Детям от 3 лет назначают по таблетке дважды в день во время еды.
Сироп
Лекарство в форме сиропа применяется для лечения аллергии взрослых и детей в возрасте от 6 месяцев. Взрослым и детям старше 3 лет назначают по 5 мл сиропа дважды (утром и вечером). Взрослым можно постепенно увеличить дозу до 10 мл сиропа 2 раза в день. Детям от 6 месяцев до 3 лет разовая доза назначается из расчета 0,25 мл на 1 кг массы тела 2 раза в течение суток.
Взрослым и детям старше 3 лет при аллергическом конъюнктивите рекомендовано закапывать по 1 капле в нижний конъюнктивальный мешок 2 раза в сутки. Из–за недостаточной изученности безопасности и эффективности применения офтальмологических капель у детей младше 3 лет не следует назначать препарат пациентам этого возраста. При закапывании необходимо избегать соприкосновения дозатора с роговицей и прилегающими тканями. Такой контакт может загрязнить раствор.
Особые указания
Препарат не очень эффективен для прекращения приступов удушья при бронхиальной астме, а также при лечении острых форм аллергической реакции. В начале приема Кетотифена рекомендуется продолжать ранее начатое лечение противоастматическими препаратами, особенно кортикостероидами. Отмечалось развитие адренокортикальной недостаточности у больных со стероидной зависимостью. Наибольший терапевтический эффект от препарата отмечается через несколько недель систематического приема.
В случае возникновения интеркуррентной (случайно присоединившейся) инфекции показано специфическое противоинфекционное лечение. Терапию препаратом следует проходить под наблюдением врача из–за возможности возникновения судорог. Пациентам с эпилепсией в анамнезе медикамент назначается с осторожностью, так как возможно снижение судорожного порога. Особый контроль необходим и при назначении терапии больным с нарушениями функции печени.
Статьи по теме
- Формидрон – инструкция по применению, побочные эффекты, противопоказания, механизм действия и аналоги
- Цефтазидим – инструкция по применению и отзывы
- Платифиллин – инструкция по применению, дозировка, механизм действия, противопоказания и отзывы
Препарат усиливает чувствительность бета-2 адренергических рецепторов, из-за чего его применяют в бодибилдинге и для похудения.
Нормализация функции гипофиза и надпочечников может продолжаться до 1 года. Поэтому в первые недели применения Кетотифена ранее назначенное лечение необходимо продолжать, а отменять постепенно и на протяжении длительного периода. Лечение препаратом следует прекращать в течение 2–4 недель, уменьшая дозу, чтоб предотвратить рецидив бронхиальной астмы. За 10–14 дней перед проведением кожных тестов прием лекарства необходимо отменить.
Кетотифен при беременности
Клинические исследования при лечении препаратом беременных не проводились. Его возможно назначать только в критических случаях, когда ожидаемая польза для здоровья и жизни матери выше, чем потенциальный риск для плода. Прием препарата запрещен в первом триместре беременности. Лекарство выделяется в грудное молоко, в случае необходимости терапии грудное вскармливание следует немедленно прекратить.

Кетотифен детям
Таблетированная форма и офтальмологические капли назначаются детям от 3 лет. Детям с 6 месяцев препарат назначается в сиропе. Разовая доза определяется из расчета 0,25 мг активного вещества на 1кг массы тела. Лекарство дают 2 раза в сутки. При исследовании фармакокинетики у детей была установлена большая метаболизация лекарства. Учитывая это, для получения оптимального эффекта может потребоваться увеличение дозы в пересчете на килограмм массы тела.
Лекарственное взаимодействие
У больных сахарным диабетом, принимающих противодиабетические пероральные препараты, при приеме Кетотифена возможно развитие оборотной тромбоцитопении. Исходя из этого, таким пациентам следует избегать комбинации этих препаратов или принимать их при условии тщательного контроля тромбоцитов.
Необходимо избегать совместного применения с атропином или средствами с атропиноподобным действием, поскольку возникает риск возникновения задержки мочи, запора, сухости во рту.
Препарат может усилить эффекты лекарственных средств, оказывающих угнетающее действие на центральную нервную систему (снотворные, седативные). Одновременный прием с другими противоаллергическими средствами способен потенцировать эффект этих препаратов.
Кетотифен и алкоголь
Употребление этилового спирта значительно усиливает депрессивное (подавляющее, угнетающее) воздействие антигистаминного препарата на центральную нервную систему пациента. Во время прохождения всего курса терапии данным лекарственным средством употребление алкоголя в любых дозировках и проявлениях категорически недопустимо.
Побочные действия Кетотифена
В зависимости от пути попадания препарата в организм, возможно возникновение побочных эффектов. При пероральном приеме возможны:
- замедление и заторможенность реакций, ощущение усталости, сонливость, головная боль, седативный эффект, головокружение, возбуждение, раздражительность, нервозность, нарушение сна;
- сухость во рту, боли в эпигастральной области, повышение аппетита, тошнота, рвота, запор;
- синдром Стивенса–Джонсона, кожные высыпания, мультиформная эритема, тяжелые кожные реакции;
- гепатит, желтуха, повышение уровня печеночных ферментов;
- дизурия, цистит.
При лечении конъюнктивально возможно возникновение как местных, так и общих побочных явлений. К ним относятся:
- гиперемия конъюнктивы, конъюнктивит, аллергические реакции, головная боль, боль в глазах, сухость слизистой оболочки глаза, жжение глаз, выделения из глаз, нарушения со стороны век, кератит, нарушение слезоотделения, мидриаз, фотофобия;
- ринит, гриппоподобный синдром, фарингит.
При передозировке может возникнуть гипотензия, головокружение, сонливость, рвота, тошнота, судороги у детей. В данном случае необходимо принять общие меры по устранению не абсорбированного количества лекарственного средства: вызвать рвоту,путем промывания желудка. При необходимости показано проведение симптоматического лечения и контроль сердечно-сосудистой и дыхательной систем.
Противопоказания
Кетотифен для перорального применения содержит лактозу. Его не следуют назначать пациентам, страдающим наследственными формами непереносимости галактозы, синдромом глюкозо–галактозной мальабсорбции, дефицитом лактозы. Поскольку препарат обладает седативным эффектом, запрещено управление автомобилем и работа с агрегатами, требующими концентрации внимания, на протяжении всего периода терапии.
Условия продажи и хранения
Медикамент отпускается по рецепту врача. Хранить препарат необходимо в сухом, недоступном для детей месте при температуре от +15 до +20 градусов С.
Аналоги
Для лечения аллергических реакций применяют ряд препаратов с тем же действующим веществом, что и у Кетотифена. К таким препаратам относят:
- Задитен. Таблетки, глазные капли, сироп. По фармакодинамике, показаниям, противопоказаниям и дозировке аналогичен Кетотифену.
- Кетоф. Таблетки, глазные капли, сироп. По способу действия, показаниям, противопоказаниям и побочным эффектам аналогичен Кетотифену.
- Позитан. Таблетки, глазные капли, сироп. По фармакодинамике, показаниям, противопоказаниям и дозировке аналогичен Кетотифену.
- Стафен. Таблетки, глазные капли, сироп. По способу действия, показаниям, противопоказаниям, схеме терапии аналогичен Кетотифену
- Френасма. Таблетки, глазные капли, сироп. Аналог Кетотифена.

Цена Кетотифена
По состоянию на 15.04.2018г у офтальмологических капель Кетотифен истек срок регистрационного свидетельства, и в продаже они отсутствуют. Ниже указаны цены на таблетки и сироп в аптеках г. Москва.
|
Аптека |
Цена, р. |
|
|
таблетки |
сироп |
|
|
Диалог |
67 |
69 |
|
Ригла |
55 |
66,5 |
|
Еврофарм |
65 |
75 |
|
Озерки |
32 |
79 |
|
Окно помощи |
77 |
88 |
|
Живика |
66 |
64 |
Видео
Отзывы
Виктория, 27 лет
У дочки (2 года) был атопический дерматит. Посыпало щеки, были покраснения в складочках. Очень все чесалось. Педиатр назначил сироп Кетотифен для детей. Пили по 2 раза в день на завтрак и с ужином по 2,5 мл. Вкус приятный, дочка пила спокойно. Лечились 2 месяца. Зуд и высыпания на коже прошли. Лечились долго, но результат того стоил.
Ольга, 35 лет
Я больше 20 лет спасаюсь Кетотифеном. Начала использовать маленькой, когда не было выбора антигистаминов. У меня аллергия на цвет черемухи – насморк, слезы, отекают слизистые. Препарат снимает все проявления, сонливости не вызывает. Принимаю до начала цветения. С моей точки зрения, идеальное соотношение цены и качества при отличном результате.
Внимание!
Информация, представленная в статье, носит ознакомительный характер. Материалы статьи не призывают к самостоятельному лечению. Только квалифицированный врач может поставить диагноз и дать рекомендации по лечению, исходя из индивидуальных особенностей конкретного пациента.
Частые вопросы
Что лечит препарат Кетотифен?
Показания Кетотифен профилактика и лечение острого, подострого и хронического аллергического конъюнктивита и кератоконъюнктивита, сезонного (весеннего) конъюнктивита, глазных проявлений сенной лихорадки.
Когда надо пить Кетотифен?
Внутрь, во время еды, запивая водой. Взрослые: по 1 таблетке (1 мг) 2 раза в день, утром и вечером. Для пациентов, у которых наблюдается значительный седативный эффект, рекомендуется медленное повышение дозы в течение первой недели, начиная с 0,5 мг вечером перед сном, до постепенного достижения терапевтической дозы.
Как помогает Кетотифен от кашля?
Кетотифен вызывает неконкурентную блокаду Н1-гистаминовых рецепторов. Эффективно предупреждает бронхоспазм, уменьшает потребность в применении ГКС, бронходилататоров. Бронхолитическим действием не обладает. Терапевтический эффект после приема препарата развивается медленно, в течение 1–2 мес.
Можно ли пить Кетотифен на ночь?
Взрослым — по 1 таблетке (1 мг) 2 раза в день (утром и вечером).
Полезные советы
СОВЕТ №1
Перед началом применения кетотифена обязательно проконсультируйтесь с врачом, чтобы убедиться, что препарат подходит именно вам, и чтобы получить рекомендации по дозировке и режиму приема.
СОВЕТ №2
Следуйте инструкции по применению кетотифена и не превышайте рекомендуемую дозу. Это поможет избежать возможных побочных эффектов и обеспечит максимальную эффективность лекарства.
СОВЕТ №3
Внимательно изучите отзывы других пациентов о применении кетотифена, чтобы понять их опыт и возможные нюансы использования препарата. Однако помните, что реакция на лекарство у каждого человека индивидуальна, поэтому не следует полностью полагаться только на отзывы.